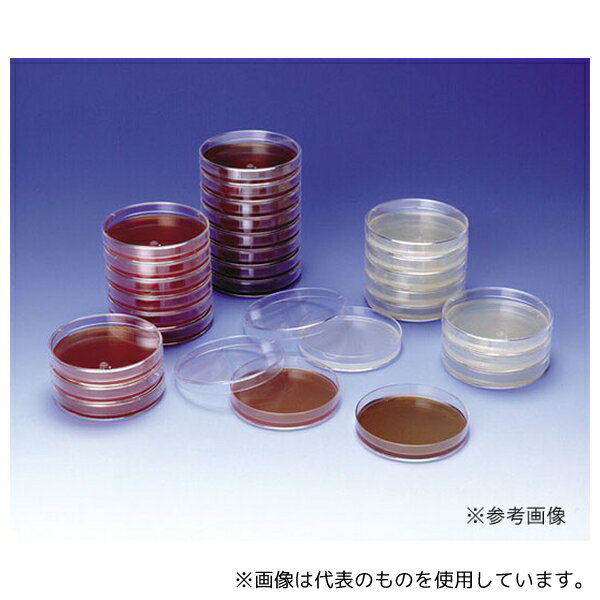
栄研化学 E-MP21 生培地 ポアメディア 普通寒天培地 10枚
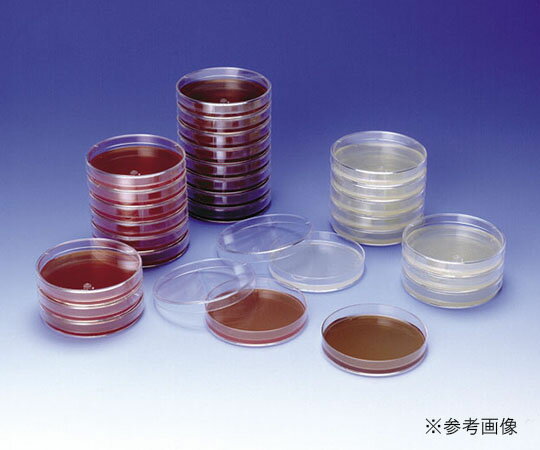
栄研化学(Eiken) 生培地 ポアメディア CP加ポテトデキストロース寒天 8-MR31 1パック(10枚入)

「花・ガーデン・DIY > DIY・工具」の商品をご紹介します。

【AS ONE】分析・特殊機器|分析機器その他島津ダイアグノスティクス 5037 アキュディアTM MacConkey寒天培地 顆粒 (マッコンキー寒天培地) 300 g
【アズワン AS ONE】分析・特殊機器 分離・分析ロシ 分析機器その他 ●日本薬局方準拠培地 ●腸内細菌分離用 商品の仕様 ●内容量:300g ●重量:400g ●※保存方法:室温・防湿 ●※有効期限:製造より3年 ●JANコード:4987302050376 【※ご注意ください】商品は代表の画像を使用しています。
7293 円 (税込 / 送料込)

【AS ONE】分析・特殊機器|分析機器その他ベクトン・ディッキンソン 244520 BD Difco(TM) LB寒天培地ミラー(Luria - Bertani)
【アズワン AS ONE】分析・特殊機器 分離・分析ロシ 分析機器その他 ●分子生物学試験で使用する大腸菌の培養および保存用の培地です。 ●塩化ナトリウムを10g/L含有します。 商品の仕様 ●粉末培地 ●用途:大腸菌用 ●質量:500g ●JANコード:382902445203 【※ご注意ください】商品は代表の画像を使用しています。
20240 円 (税込 / 送料込)

【AS ONE】分析・特殊機器|分析機器その他ベクトン・ディッキンソン 252029 BD BBL(TM) YSG寒天培地 1個(1本×20枚入)
【アズワン AS ONE】分析・特殊機器 分離・分析ロシ 分析機器その他 ●飲料や原材料からAlicyclobacillus属細菌の分離用培地です。 商品の仕様 ●生培地 ●用途:食品検査用 ●入数:20枚入 ●JANコード:382902520290 【※ご注意ください】商品は代表の画像を使用しています。
7238 円 (税込 / 送料込)

【AS ONE】分析・特殊機器|分析機器その他ベクトン・ディッキンソン 251173 BD BBL(TM) マンニット食塩寒天培地 20枚
【アズワン AS ONE】分析・特殊機器 分離・分析ロシ 分析機器その他 ●マンニット食塩寒天培地は、Staphylococcus、とくに黄色ブドウ球菌の選択分離に用いられます 商品の仕様 ●生培地 ●用途:グラム陽性球菌用 ●入数:20枚入 ●JANコード:382902511731 【※ご注意ください】商品は代表の画像を使用しています。
7117 円 (税込 / 送料込)

【AS ONE】分析・特殊機器|分析機器その他栄研化学 E-MC70 粉末培地(ボトル) SCDLP寒天培地
【アズワン AS ONE】分析・特殊機器 分離・分析ロシ 分析機器その他 ●医薬品・化粧品検査用 商品の仕様 ●粉末 ●内容量:100g ●JANコード:4987026238432 【※ご注意ください】商品は代表の画像を使用しています。
7128 円 (税込 / 送料込)

【AS ONE】分析・特殊機器|培地等Merck 1.46004.0120 好気性微生物試験培地 SCD寒天培地 30mL 1箱(120枚入)
【アズワン AS ONE】分析・特殊機器 培養機器・容器 培地等 ●日本薬局方適合の生培地です。 商品の仕様 ●型番:1.46004.0120 ●培地名:SCD寒天培地 ●容量(mL):30 ●入数:1箱(120枚入) ●※保存温度:-01/2~25℃、その他/15~25℃ ●※有効期限:1.46458.0010/12ヶ月、その他/6ヶ月 ●JANコード:0 【※ご注意ください】商品は代表の画像を使用しています。
41910 円 (税込 / 送料込)

【AS ONE】分析・特殊機器|分析機器その他極東製薬工業 5775 バイタルメディア GVPC寒天培地 5枚
【アズワン AS ONE】分析・特殊機器 分離・分析ロシ 分析機器その他 ●レジオネラ選択分離用 商品の仕様 ●生培地 ●保管温度210℃ ●JANコード:4987551057751 【※ご注意ください】商品は代表の画像を使用しています。
3036 円 (税込 / 送料別)

【AS ONE】分析・特殊機器|分析機器その他ベクトン・ディッキンソン 247940 BD Difco(TM) プレートカウント寒天培地(標準寒天培地)
【アズワン AS ONE】分析・特殊機器 分離・分析ロシ 分析機器その他 ●標準法に使われる寒天培地です。 ●水道、排水、食品および乳製品中の細菌数測定用です。 商品の仕様 ●粉末培地 ●用途:一般細菌用 ●質量:500g ●JANコード:382902479406 【※ご注意ください】商品は代表の画像を使用しています。
18810 円 (税込 / 送料込)

【送料無料】アズワン 粉末培地 (マンニット食塩寒天) 500g6-8814-01 ※事業者向け商品です
メーカー アズワン 商品カテゴリ 机上用品・文具収納>拡大鏡・ルーペ 発送目安 1日~2日以内に発送予定(土日祝除) お支払方法 銀行振込・クレジットカード 送料 送料無料 特記事項 その他 ●培地名:マンニット食塩寒天●適合:食品中のStaphylococcusspp.の検出●容量:500g●保存方法:15~25°C
9796 円 (税込 / 送料込)

【AS ONE】分析・特殊機器|分析機器その他ベクトン・ディッキンソン 251302 BD BBL(TM) TSAII5%ヒツジ血液寒天培地/チョコレートII寒天培地 20枚
【アズワン AS ONE】分析・特殊機器 分離・分析ロシ 分析機器その他 ●本培地は、1枚で2種類の培地が併用できる様に組合わされた便利で効率の良い培地で、発育性、溶血反応にすぐれた一般分離用のTSAII5%ヒツジ血液寒天培地とHaemophilus、Neisseria などの栄養要求の厳しい菌の分離培養に最適なチョコレートII 寒天培地の組合わせです 商品の仕様 ●生培地(分画培地) ●入数:20枚入 ●JANコード:382902513025 【※ご注意ください】商品は代表の画像を使用しています。 【※ご注意ください】0
7700 円 (税込 / 送料別)

【AS ONE】分析・特殊機器|分析機器その他栄研化学 E-MP21 生培地 ポアメディア 普通寒天培地 10枚
【アズワン AS ONE】分析・特殊機器 分離・分析ロシ 分析機器その他 ●一般細菌検査用 商品の仕様 ●入数:10枚入 ●JANコード:4987026129495 【※ご注意ください】商品は代表の画像を使用しています。
2090 円 (税込 / 送料別)

【AS ONE】分析・特殊機器|分析機器その他島津ダイアグノスティクス 51050 アキュレート?ガンマ線SCDLP寒天培地ーN (二重包装単位) 10枚
【アズワン AS ONE】分析・特殊機器 分離・分析ロシ 分析機器その他 ●日本薬局方準拠培地 ●一般生菌数測定用(不活化剤含有) 商品の仕様 ●入数:10枚 ●重量:400g ●※保存方法:4~10℃(凍結不可) ●有効期限:製造後5ヶ月 ●★1枚あたりのサイズ:蓋φ89.5×全高14.5mm ●JANコード:4987302510504 【※ご注意ください】商品は代表の画像を使用しています。
3179 円 (税込 / 送料別)

【AS ONE】分析・特殊機器|分析機器その他ベクトン・ディッキンソン 252029 BD BBL(TM) YSG寒天培地 1個(1本×20枚入)
【アズワン AS ONE】分析・特殊機器 分離・分析ロシ 分析機器その他 ●飲料や原材料からAlicyclobacillus属細菌の分離用培地です。 商品の仕様 ●生培地 ●用途:食品検査用 ●入数:20枚入 ●JANコード:382902520290 【※ご注意ください】商品は代表の画像を使用しています。
7238 円 (税込 / 送料込)

【送料無料】アズワン サニスペック生培地 卵黄加マンニット食塩寒天 100枚入
メーカー アズワン 商品カテゴリ 実験用器具・消耗品>実験用消耗品 発送目安 1日~2日以内に発送予定(土日祝除) お支払方法 銀行振込・クレジットカード 送料 送料無料 特記事項 その他
10076 円 (税込 / 送料込)

【AS ONE】分析・特殊機器|分析機器その他島津ダイアグノスティクス 5835 粉末寒天 500g入
【アズワン AS ONE】分析・特殊機器 分離・分析ロシ 分析機器その他 ●本品は、細菌検査に適するように生成された粉末寒天である。 ●細菌の発育に影響を及ぼすような成分をほとんど含まず、一般細菌試験に好適である。 ●また、ゼリー強度が大きく、経済的である。 商品の仕様 ●包装:500g ●貯蔵方法:室温に保存(要防湿) ●サイズ:W12cm×H15cm×D12cm ●JANコード:4987302058358 【※ご注意ください】商品は代表の画像を使用しています。
15400 円 (税込 / 送料込)

【AS ONE】分析・特殊機器|分析機器その他●栄研化学 E-MG16 粉末培地(ボトル) BL寒天培地
【アズワン AS ONE】分析・特殊機器 分離・分析ロシ 分析機器その他 ●Bifidobacteriumの生菌数測定用、嫌気生菌分離用 商品の仕様 ●粉末 ●内容量:300g ●JANコード:4987026118956 【※ご注意ください】商品は代表の画像を使用しています。
18150 円 (税込 / 送料込)

【AS ONE】分析・特殊機器|分析機器その他栄研化学 E-MD03 粉末培地(ボトル顆粒) パールコア(R) TCBS寒天培地
【アズワン AS ONE】分析・特殊機器 分離・分析ロシ 分析機器その他 ●コレラ菌・腸炎ビブリオ分離用 商品の仕様 ●顆粒 ●内容量:300g ●JANコード:4987026099101 【※ご注意ください】商品は代表の画像を使用しています。
7788 円 (税込 / 送料込)

【AS ONE】分析・特殊機器|培地等Merck 1.13116.0500 酵母エキス寒天培地(ISO 6222およびSwedish Standard SS 028171に準拠) 微生物学用 113116 500G
【アズワン AS ONE】分析・特殊機器 培養機器・容器 培地等 商品の仕様 ●※国内外の在庫状況により納期が表記と異なる事がございますことご了承ください。 ●JANコード:4022536147185 【※ご注意ください】商品は代表の画像を使用しています。
53460 円 (税込 / 送料込)
【AS ONE】分析・特殊機器|分析機器その他栄研化学 E-MP21 生培地 ポアメディア 普通寒天培地 10枚
【アズワン AS ONE】分析・特殊機器 分離・分析ロシ 分析機器その他 ●一般細菌検査用 商品の仕様 ●入数:10枚入 ●JANコード:4987026129495 【※ご注意ください】商品は代表の画像を使用しています。
2090 円 (税込 / 送料別)

【AS ONE】分析・特殊機器|分析機器その他極東製薬工業 6810 バイタルメディア YSG寒天培地 20枚
【アズワン AS ONE】分析・特殊機器 分離・分析ロシ 分析機器その他 ●TAB(耐熱性好酸性菌)分離用 商品の仕様 ●生培地 ●保管温度210℃ ●JANコード:4987551068108 【※ご注意ください】商品は代表の画像を使用しています。
4609 円 (税込 / 送料込)

【AS ONE】分析・特殊機器|分析機器その他島津ダイアグノスティクス 5040 アキュディア DHL寒天培地(顆粒)300g入
【アズワン AS ONE】分析・特殊機器 分離・分析ロシ 分析機器その他 ●本培地は、病原腸内細菌(Salmonella、赤痢菌(Shigella)等)の選択分離培地であり、臨床検査材料および食品からの検出を目的に使用する。 ●SS寒天培地より選択性が弱いため、SS寒天培地上に発育し難い赤痢菌、Salmonellaが良好に発育する。 商品の仕様 ●包装:300g ●貯蔵方法:室温に保存(要防湿) ●サイズ:W9cm×H20cm×D9cm ●JANコード:4987302050406 【※ご注意ください】商品は代表の画像を使用しています。
7238 円 (税込 / 送料込)

【AS ONE】分析・特殊機器|分析機器その他ベクトン・ディッキンソン 251524 BD ロダック(TM) プレート CP添加サブロー寒天培地 1個(1本×30枚入)
【アズワン AS ONE】分析・特殊機器 分離・分析ロシ 分析機器その他 ●食品製造環境及び調理、従事者向けのスタンプ式の培地です。 商品の仕様 ●生培地 ●コンタクトプレート ●入数:30枚入 ●JANコード:382902515241 【※ご注意ください】商品は代表の画像を使用しています。
6963 円 (税込 / 送料込)
【送料無料】栄研化学(Eiken) 生培地 ポアメディア CP加ポテトデキストロース寒天 8-MR31 1パック(10枚入)
メーカー 栄研化学(Eiken) 商品カテゴリ 実験用器具・消耗品>実験用消耗品 発送目安 1日~2日以内に発送予定(土日祝除) お支払方法 銀行振込・クレジットカード 送料 送料無料 特記事項 その他
2606 円 (税込 / 送料込)

【AS ONE】分析・特殊機器|微生物検査用品島津ダイアグノスティクス 5041 アキュディア? MLCB寒天培地(粉末) 300g
【アズワン AS ONE】分析・特殊機器 検査用品 微生物検査用品 商品の仕様 ●サルモネラ属菌選択分離用 ●内容量:1本(300g入) ●保存方法:室温・防湿 ●JANコード:4987302050413 【※ご注意ください】商品は代表の画像を使用しています。 【※ご注意ください】0
7194 円 (税込 / 送料別)

【AS ONE】分析・特殊機器|分析機器その他島津ダイアグノスティクス 51057 アキュレート?XM-EHEC寒天培地 10枚
【アズワン AS ONE】分析・特殊機器 分離・分析ロシ 分析機器その他 ●本培地は、発色酵素基質を用いた腸管出血性大腸菌(EHEC)の選択分離用培地である。 ●便や食品からのEHEC O157・O26・O111の検出を目的とする。 ●EHEC O157・O26・O111が 発育時に分解する発色酵素基質と、ソルビトールを含有することで、それぞれの鑑別性を高めている。 商品の仕様 ●包装:10枚 ●貯蔵方法:4~10℃に保存(禁凍結) ●サイズ:W10cm×H10cm×D10cm ●JANコード:4987302510573 【※ご注意ください】商品は代表の画像を使用しています。 【※ご注意ください】0
3872 円 (税込 / 送料別)

【AS ONE】分析・特殊機器|分析機器その他極東製薬工業 2230 極東 TSI寒天培地 300g
【アズワン AS ONE】分析・特殊機器 分離・分析ロシ 分析機器その他 ●腸内細菌確認用培地 ●性状確認用 商品の仕様 ●粉末 ●JANコード:4987551022308 【※ご注意ください】商品は代表の画像を使用しています。 【※ご注意ください】0
7084 円 (税込 / 送料別)

【AS ONE】分析・特殊機器|分析機器その他極東製薬工業 7521 極東 CLIG寒天生培地 50本入
【アズワン AS ONE】分析・特殊機器 分離・分析ロシ 分析機器その他 ●大腸菌の確認及び、腸管出血性大腸菌O157鑑別が容易にできます。 ●高層部で乳糖からの酸産生、斜面部でセロビオースからの酸産生が確認できます。 ●培地に365nmの紫外線を照射した場合、大腸菌は青色蛍光を示しますが、腸管出血性大腸菌O157はβ-Dグルクロニダーゼ陰性のため青色蛍光を示しません。 ●また斜面部に発育した菌を用いてインドール産生を確認することができます。 商品の仕様 ●生培地 ●入数:1箱(50本入) ●貯法:4~8℃ ●有効期間:6ヶ月 ●JANコード:4987551075212 【※ご注意ください】商品は代表の画像を使用しています。 【※ご注意ください】0
6930 円 (税込 / 送料別)

【AS ONE】分析・特殊機器|分析機器その他●栄研化学 E-MB31 粉末培地(ボトル) BCP加プレートカウント寒天培地
【アズワン AS ONE】分析・特殊機器 分離・分析ロシ 分析機器その他 ●乳酸菌数測定用 商品の仕様 ●粉末 ●内容量:300g ●JANコード:4987026178301 【※ご注意ください】商品は代表の画像を使用しています。
12540 円 (税込 / 送料込)

【AS ONE】分析・特殊機器|分析機器その他栄研化学 E-MP25 生培地 ポアメディア トリプトソイ寒天 1パック(10枚入)
【アズワン AS ONE】分析・特殊機器 分離・分析ロシ 分析機器その他 ●細菌の増殖・分離用 商品の仕様 ●生培地 ●内容量:10枚 ●JANコード:4987026144030 【※ご注意ください】商品は代表の画像を使用しています。
2090 円 (税込 / 送料別)

【AS ONE】分析・特殊機器|分析機器その他島津ダイアグノスティクス 51053 アキュレートチョコレート寒天培地-EXII10枚
【アズワン AS ONE】分析・特殊機器 分離・分析ロシ 分析機器その他 ●本培地は、Haemophilus、Neisseriaなどの発育要求性の厳しい菌の分離培養、および増菌培養のために使用する。 ●ゴノコッカス(GC)寒天基礎培地にヘモグロビン末とCLSI M22-A3発育因子を加え、発育支持力を強化した培地である。 商品の仕様 ●包装:10枚 ●貯蔵方法:4~10℃に保存(禁凍結) ●サイズ:W10cm×H10cm×D10cm ●JANコード:4987302510535 【※ご注意ください】商品は代表の画像を使用しています。
2937 円 (税込 / 送料別)
